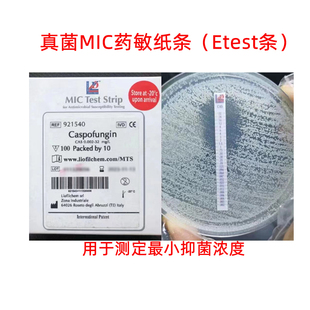
意大利进口梯度定量真菌药敏条etest梅里埃同款mic抑菌浓度测定

海氏海诺验孕棒高精度测孕卡排卵纸验孕试纸早孕测定纸怀孕检测


艾早现5-羟吲哚乙酸测定试剂癌症早筛癌症检测试剂肿瘤风险筛查


群隆密度天平固体密度测定仪金属塑料橡胶颗粒电缆测量液体比重计


浊度标准溶液浊度仪校正液浊度液水质浊度测定福尔马肼-4000NTU


倍弗农狗猪牛用排卵测定猪用排卵测定仪犬狗发情检测仪猪配种仪器


玻璃棉 石油类的测定 玻璃纤维棉 硅酸镁吸附柱填充 过滤 实验室


便携式手持cod检测仪污水氨氮总磷总氮水质多参数快速分析测定仪


浊度标准溶液浊度仪校正液浊度液水质福尔马肼0NTU-4000NTU测定


Labshark BCA法蛋白定量试剂盒蛋白浓度测定检测盒500T源叶索莱宝


月桂基硫酸盐胰蛋白胨肉汤(LST)培养基 大肠杆菌大肠菌群的测定


便携式污水水质检测仪cod氨氮PH余氯浊度总磷总氮重金属快速测定


水硬度检测仪锅炉水便携式总碱度测定仪氯化物循环水软化水分析仪


海创高科钢筋位置扫描仪一体式钢筋测定仪混凝土钢筋位置检测仪


鲁哥氏碘液 浮游植物的测定专用 国标HJ1215-2021 科研试剂 500mL


流动性松装密度测定装置(漏斗法),流动性松装密度测定仪


意大利哈纳HANNA-HI2020便捷式PH计水质PH测定计


防水卷材加热伸缩测定仪防水涂料加热伸缩测伸缩量高分子试验装置


马铃薯直链淀粉标准溶液 支链淀粉溶液 大米淀粉含量测定 1mg/mL


路面渗水仪沥青路面渗水量测定渗透系数沥青混合料渗水系数测定仪


热变形维卡软化点测定仪塑料橡胶尼龙热变形维卡软化点温度测定仪


溶解氧检测仪传感器便携式荧光法在线水质溶解氧测定仪485高精度


祈工 QSG铁钴比色计清漆清油稀料剂颜色的测定比色计比色仪GB1722


混凝土碳化深度测量仪HT-2-1型数显回弹仪碳化深度测定仪检测尺器


格锐思生物 多糖含量测定试剂盒(苯酚-硫酸法) G0593F分光法


众科创谱 COD测定仪多参数水质检测仪氨氮总磷总氮重金属检测仪


施特驰 SR-100 光学盐度计海缸纯铜机芯 耐腐蚀测定精准 海水专用


NB-1型泥浆比重计粘度计密度泥浆称含砂量计测定仪ANY-1型3三件套


台湾衡欣TDS水质硬度测试带电导率检测EC值计电导率测定仪测试仪


5%卢戈氏碘液鲁戈氏碘液复方碘溶液革兰氏染色液淀粉测定实验包邮


在线荧光法溶解氧传感器便携式工业水产养殖含氧量分析测定检测仪


陆恒便携式余氯检测仪泳池余氯测定仪消毒残余污废水有效氯检测仪


数显旋转粘度计测量仪涂料油漆墨黏度计液体指针粘度测试测定仪


硫酸汞溶液 测定耗氧量消除氯离子干扰 定氮催化剂 化学实验试剂


华畜狗用排卵检测仪犬用排卵仪母猪备孕发情检测母犬排卵测定仪


居测血糖/血酮/尿酸/血脂联合测定试剂盒


真空蒸馏仪蒸馏烧瓶500ml石油产品蒸馏减压测定法GB/T9168-1997


2,6-二氯靛酚钠溶液500mL水果蔬菜维生素C测定2,6-二氯靛酚滴定法

意大利进口梯度定量真菌药敏条etest梅里埃同款mic抑菌浓度测定


上海雷磁电导率仪DDS-11A/307A/307实验室数显电导率纯水测定仪


便携式手持余氯检测仪器水质多参数总氯污水自来水泳池分析测定仪

